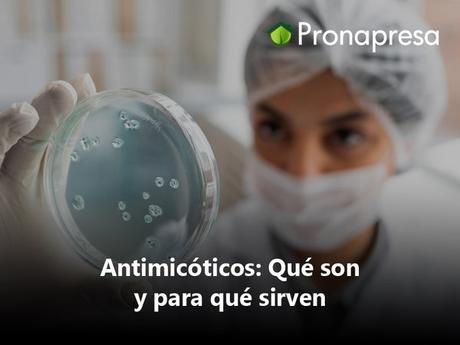
Antimicóticos: Qué son y para qué sirven

Los antimicóticos son un grupo de medicamentos esenciales en el campo de la medicina que se utilizan para combatir las infecciones causadas por hongos. Al igual que las bacterias, los hongos son microorganismos que pueden provocar diversas enfermedades en los seres humanos y otros organismos. Estas infecciones fúngicas pueden afectar la piel, las uñas, las membranas mucosas y, en casos más graves, incluso los órganos internos.
¿Qué son los antimicóticos?
Los antimicóticos son compuestos químicos diseñados específicamente para atacar y eliminar los hongos patógenos que causan infecciones en los seres vivos. Al igual que con los antibióticos que combaten las bacterias, los antimicóticos actúan de diversas maneras para inhibir el crecimiento y la propagación de los hongos. Pueden interferir con la síntesis de la pared celular del hongo, bloquear la síntesis de sus componentes vitales o perturbar sus procesos metabólicos, lo que finalmente lleva a la muerte del hongo.
Tipos de Antimicóticos: Existen varios tipos de antimicóticos, y se dividen en dos categorías principales: los antimicóticos sistémicos y los antimicóticos tópicos.
Los antimicóticos son un grupo de medicamentos esenciales en el campo de la medicina que se utilizan para combatir las infecciones causadas por hongos. Al igual que las bacterias, los hongos son microorganismos que pueden provocar diversas enfermedades en los seres humanos y otros organismos. Estas infecciones fúngicas pueden afectar la piel, las uñas, las membranas mucosas y, en casos más graves, incluso los órganos internos.
¿Qué son los antimicóticos?
Los antimicóticos son compuestos químicos diseñados específicamente para atacar y eliminar los hongos patógenos que causan infecciones en los seres vivos. Al igual que con los antibióticos que combaten las bacterias, los antimicóticos actúan de diversas maneras para inhibir el crecimiento y la propagación de los hongos. Pueden interferir con la síntesis de la pared celular del hongo, bloquear la síntesis de sus componentes vitales o perturbar sus procesos metabólicos, lo que finalmente lleva a la muerte del hongo.
Tipos de Antimicóticos: Existen varios tipos de antimicóticos, y se dividen en dos categorías principales: los antimicóticos sistémicos y los antimicóticos tópicos.
-
Antimicóticos Sistémicos: Estos se utilizan para tratar infecciones fúngicas más profundas y generalizadas que pueden afectar órganos internos. Se administran por vía oral o intravenosa y entran en el torrente sanguíneo para combatir las infecciones que están más allá de la superficie de la piel. Ejemplos de antimicóticos sistémicos incluyen fluconazol, itraconazol y anfotericina B.
-
Antimicóticos Tópicos: Estos se aplican directamente sobre la piel, uñas o membranas mucosas para tratar infecciones fúngicas superficiales. Vienen en forma de cremas, lociones, ungüentos y polvos. Son efectivos para tratar infecciones como el pie de atleta, la candidiasis vaginal y las infecciones de la piel. Ejemplos de antimicóticos tópicos son el clotrimazol, miconazol y terbinafina.
Usos y Beneficios: Los antimicóticos son vitales para el tratamiento de una amplia gama de infecciones fúngicas que pueden afectar la calidad de vida de las personas. Algunas infecciones superficiales pueden causar picazón, enrojecimiento y malestar general, mientras que las infecciones sistémicas pueden ser potencialmente mortales en individuos con sistemas inmunológicos comprometidos. Los antimicóticos ayudan a aliviar los síntomas, prevenir la propagación de la infección y mejorar la salud general del paciente.
En resumen, los antimicóticos son una herramienta esencial en la lucha contra las infecciones fúngicas, desde las superficiales hasta las sistémicas. Gracias a estos medicamentos, es posible tratar eficazmente las infecciones por hongos, mejorar la calidad de vida de los pacientes y prevenir complicaciones más graves. Siempre es recomendable consultar a un profesional de la salud para un diagnóstico y tratamiento adecuados en caso de sospecha de infección fúngica.
Recuerda que prevenir es mejor que curar


